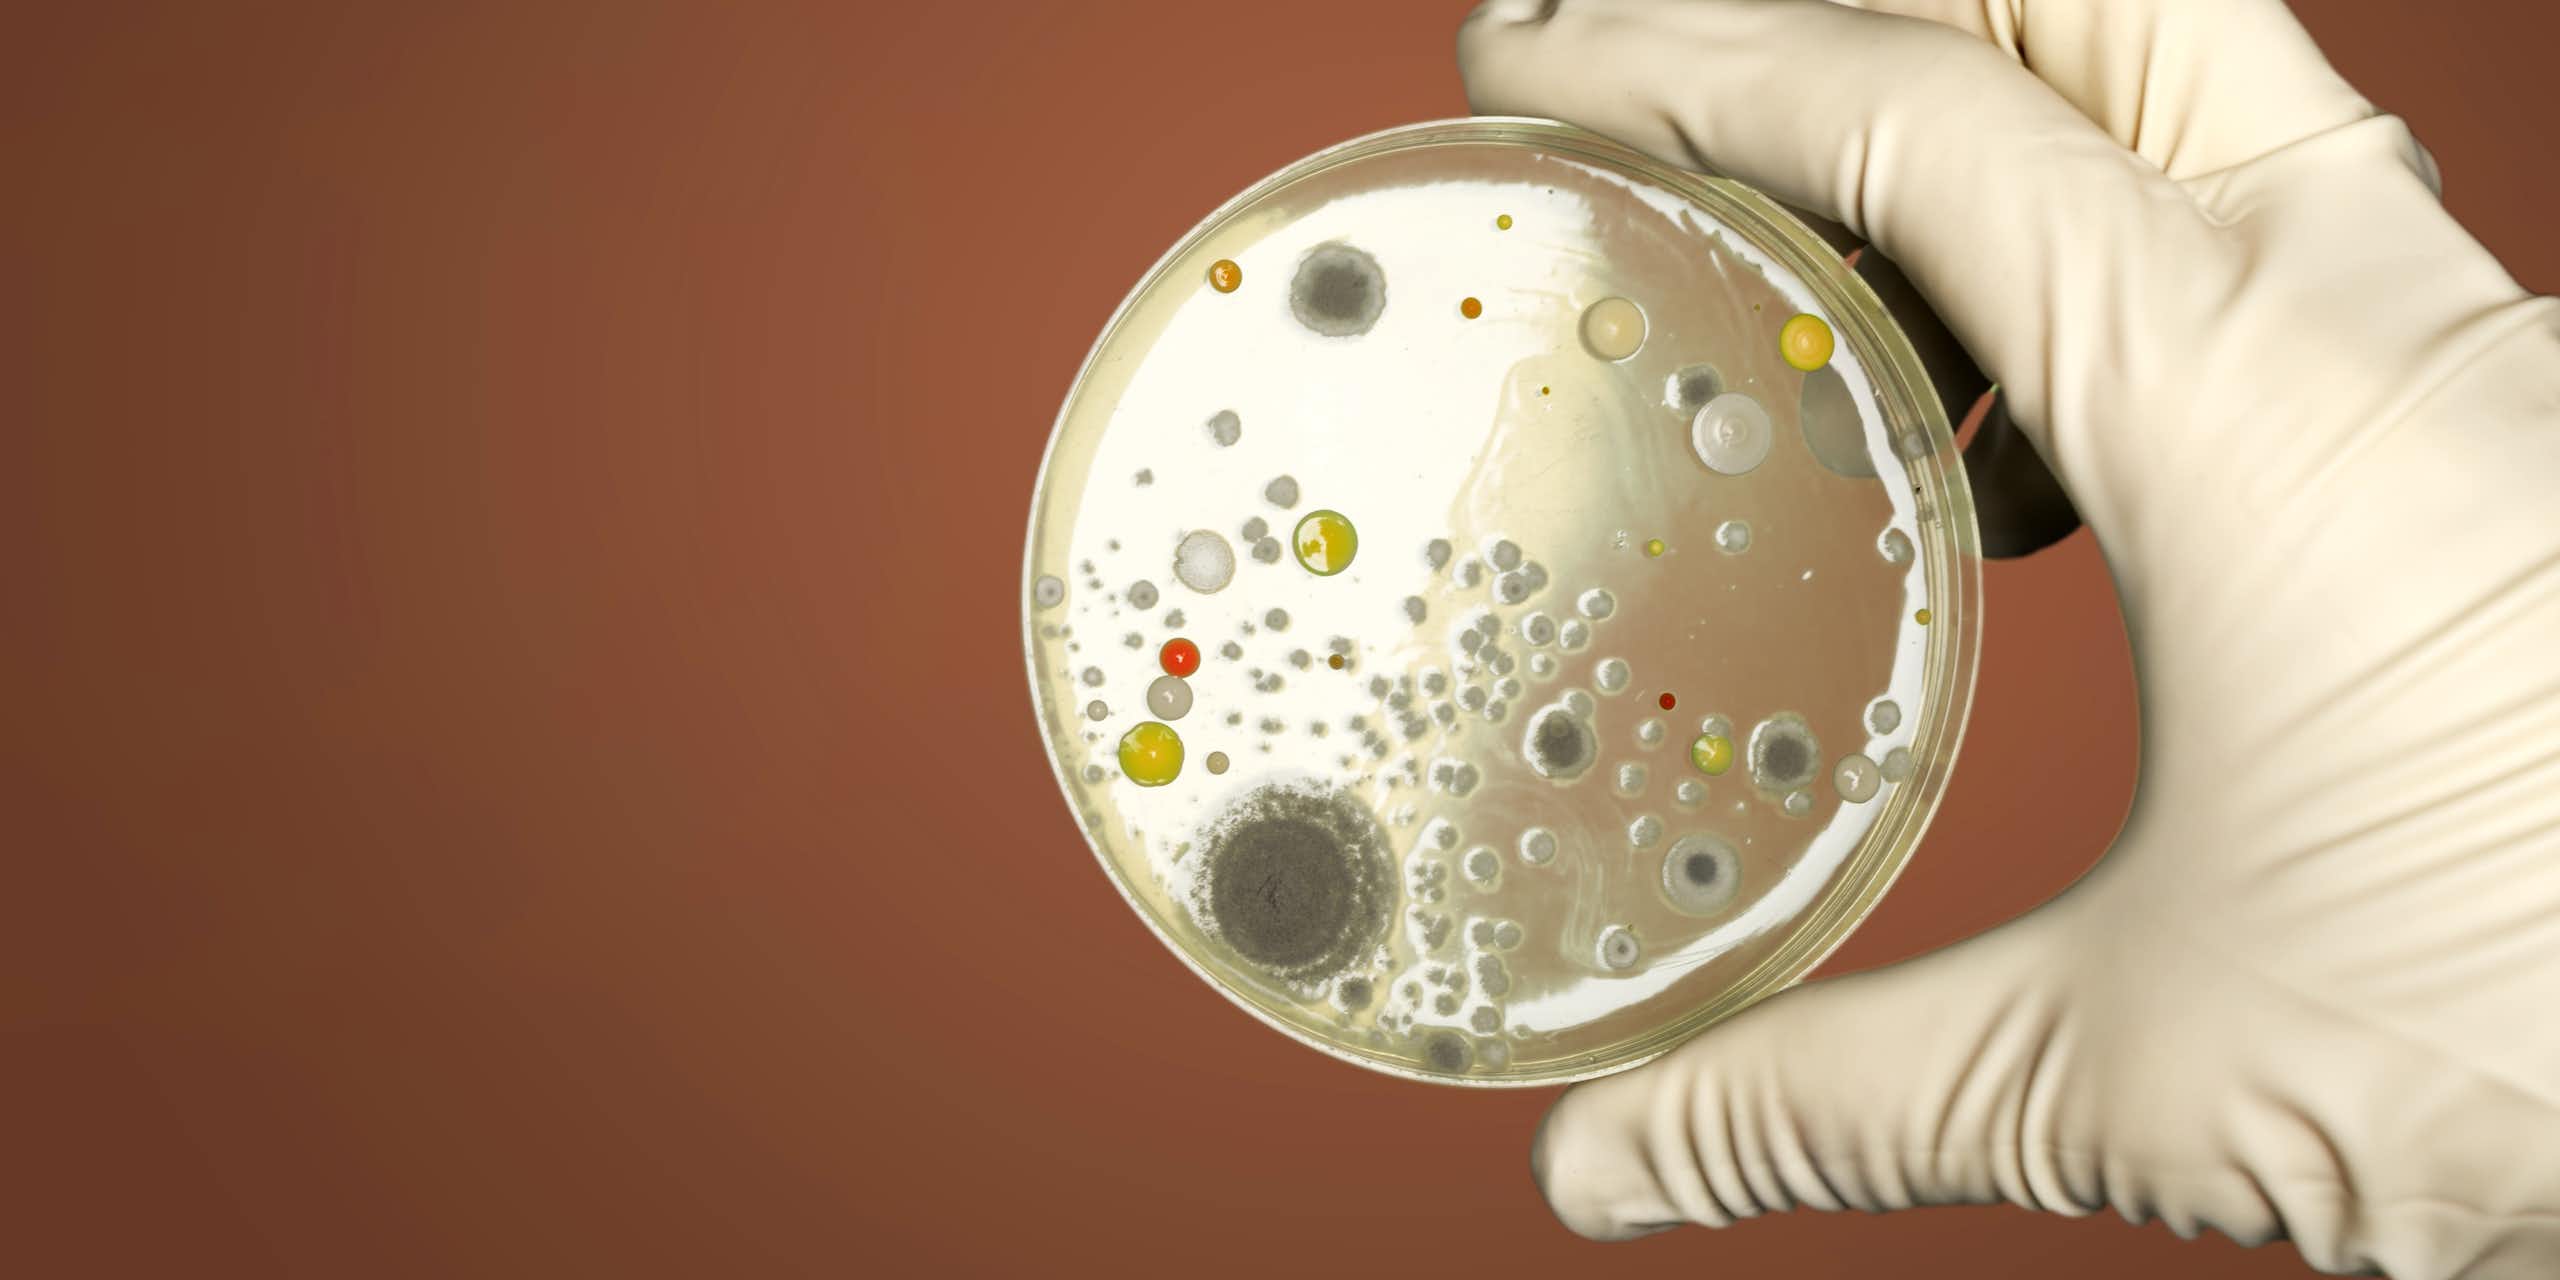
Une main gantée tenant une boîte

Support our non-profit, independent journalism in Canada with a charitable donation
Donate todayIn case you missed it
Join The Conversation Canada on Bluesky
Follow usThe latest news and analysis delivered to your inbox
Sign up for our newsletterQuarter Life
Podcasts
Dive into conversations with experts and real people to make sense of the news, from an anti-racist perspective
Follow our podcastLa Conversation Canada
Most read this week
Share knowledge. Inform decisions.
The Conversation is the world's leading publisher of research-based news and analysis. It is a unique collaboration between academics and journalists.
Free to read. Free to republish.
Partners
The Conversation is made possible with the support of our partners.
View all of our partners